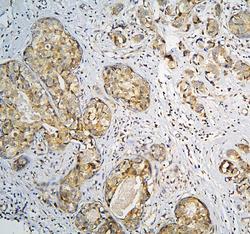

Antibody data
- Antibody Data
- Antigen structure
- References [0]
- Comments [0]
- Validations
- Immunohistochemistry [1]
Submit
Validation data
Reference
Comment
Report error
- Product number
- A12898 - Provider product page

- Provider
- Boster Biological Technology
- Product name
- Anti-CPAMD8 Antibody Picoband™
- Antibody type
- Polyclonal
- Description
- Rabbit IgG polyclonal antibody for CPAMD8 detection. Tested with WB, IHC-P, Direct ELISA in Human.
- Reactivity
- Human
- Host
- Rabbit
- Vial size
- 100μg/vial
- Concentration
- Add 0.2ml of distilled water will yield a concentration of 500ug/ml.
- Storage
- At -20°C for one year. After reconstitution, at 4°C for one month. It can also be aliquoted and stored frozen at -20°C for a longer time. Avoid repeated freezing and thawing.
- Handling
- Add 0.2ml of distilled water will yield a concentration of 500ug/ml.
No comments: Submit comment
Supportive validation
- Submitted by
- Boster Biological Technology (provider)
- Main image

- Experimental details
- IHC analysis of CPAMD8 using anti-CPAMD8 antibody (A12898).CPAMD8 was detected in paraffin-embedded section of human lung cancer tissue. Heat mediated antigen retrieval was performed in citrate buffer (pH6, epitope retrieval solution) for 20 mins. The tissue section was blocked with 10% goat serum. The tissue section was then incubated with 1μg/ml rabbit anti-CPAMD8 Antibody (A12898) overnight at 4°C. Biotinylated goat anti-rabbit IgG was used as secondary antibody and incubated for 30 minutes at 37°C. The tissue section was developed using Strepavidin-Biotin-Complex (SABC)(Catalog # SA1022) with DAB as the chromogen.
- Additional image